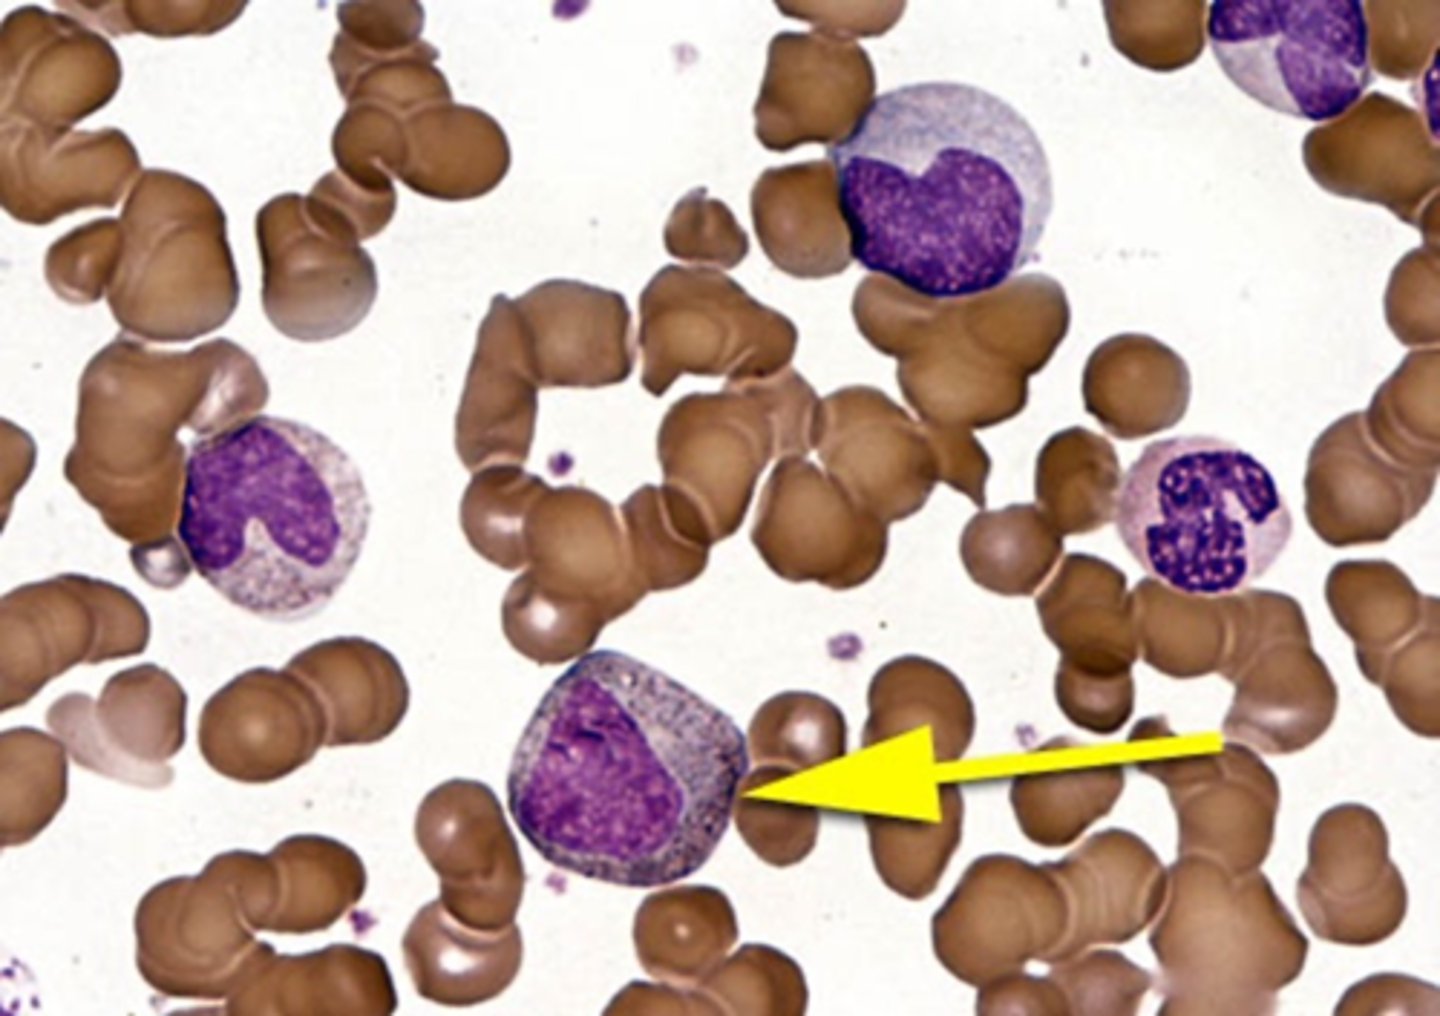

1/99
Looks like no tags are added yet.
Name | Mastery | Learn | Test | Matching | Spaced | Call with Kai |
|---|
No analytics yet
Send a link to your students to track their progress
What are leukocytes (white blood cells)?
Leukocytes are nucleated cells that protect against infections.
Where do leukocytes differentiate, proliferate, and mature?
Leukocytes differentiate, proliferate, and mature in the bone marrow, except for T lymphocytes.
What are the two main functions of leukocytes?
Innate (non-specific) immunity
Adaptive (specific) immunity
Where are leukocytes found?
found in peripheral blood and tissues.
What are granulocytes, and what are the three main types?
Granulocytes are polymorphonuclear cells (PMNs) and include:
↪ Neutrophils
↪ Eosinophils
↪ Basophils
What is the primary function of neutrophils?
Neutrophils are the most abundant in bacterial defense.

What is the primary role of eosinophils?
Eosinophils play a key role in allergy and parasitic infections.

What is the main function of basophils?
Basophils are involved in histamine release and inflammation.

What are agranulocytes, and what are the two main types?
Agranulocytes are mononuclear cells, which include:
↪ Monocytes
↪ Lymphocytes
What do monocytes differentiate into?
Monocytes differentiate into macrophages.

What are the types of lymphocytes?
B cells
T cells
NK cells
Leukocytosis
an increase in leukocytes
Leukopenia
a decrease in leukocytes
What is innate (natural) immunity, and how does it function?
the body's first response to invading pathogens, involving leukocytes that recognize pathogen-associated molecular patterns (PAMPs).
What are PAMPs (pathogen-associated molecular patterns), and what examples were provided?
PAMPs are molecular structures carried by pathogens. Examples include:
LPS
Fungal mannans
Viral RNA or DNA
How do leukocytes interact with PAMPs?
Leukocytes interact with PAMPs through pattern recognition receptors (PRRs).
What is adaptive (acquired) immunity, and how does it differ from innate immunity?
Adaptive immunity is initiated in lymphoid tissue, develops more slowly than innate immunity, and provides long-lasting immunity or memory.
Where do all leukocytes originate from?
from hematopoietic stem cells (HSCs) in the bone marrow.
What are the two major progenitors that HSCs differentiate into?
Common Myeloid Progenitor (CMP)
Common Lymphoid Progenitor (CLP)
What cell types are produced from the Common Myeloid Progenitor (CMP)?
granulocytes and monocytes.
What cell type is produced from the Common Lymphoid Progenitor (CLP)?
lymphocytes
What is granulopoiesis, and what does it require?
the formation of granulocytes, and it requires cytokines such as IL-1, IL-3, IL-6, G-CSF, and GM-CSF.
What is monocytopoiesis, and what stimulates it?
the formation of monocytes, and it is stimulated by M-CSF (monocyte colony-stimulating factor).
What happens to the nucleoli during neutrophil maturation?
disappear
How does the chromatin change as neutrophils mature?
condenses
How does the nucleus change in the maturation process?
The round nuclear mass indents and eventually segments
What is the characteristic appearance of the cytoplasm in the myeloblast stage?
canty, agranular, and basophilic.
How does the cytoplasm change during neutrophil maturation?
pink-to-neutral staining and more granular as neutrophils mature.
What are the four subsets of granules in neutrophils?
Primary
Secondary
Secretory
Tertiary
What do the granules in neutrophils contain?
specific molecules of physiologic importance
What is the size of a myeloblast, and what is its nucleus-to-cytoplasm (N:C) ratio?
14–20 μm in diameter with a high N:C ratio.

How does the nucleus of a myeloblast appear?
round or oval, with delicate, lacy, evenly stained chromatin and 1–5 visible nucleoli.

What is the appearance of the cytoplasm in a myeloblast?
small amount of blue agranular cytoplasm with a distinct unstained area adjacent to the nucleus (Golgi apparatus).

What enzymes are faintly positive in a myeloblast?
Peroxidase and esterase enzymes
How does the myeloblast compare in size to a mature RBC?
3-4 times larger than a mature RBC
What are the microscopic features of the myeloblast?
↪ High N:C ratio
↪ Round nucleus with immature chromatin (not clumped)
↪ Prominent nucleoli
↪ Scant cytoplasm that is gray to pale blue and lacks granules

What is the size and nucleus-to-cytoplasm (N:C) ratio of a promyelocyte?
15–21 μm in size with a large, high N:C ratio

How does the chromatin appear in a promyelocyte?
coarser than in a myeloblast, but still open and lacy.
How many nucleoli are present in a promyelocyte?
several nucleoli

What is the appearance of the cytoplasm in a promyelocyte?
basophilic, with prominent reddish-purple primary granules (nonspecific granules).

What do the granules in a promyelocyte contain?
peroxidase and antimicrobial compounds
What are the microscopic features of a promyelocyte?
↪ High N:C ratio (but more cytoplasm than a myeloblast)
↪ Round nucleus with immature chromatin (not clumped)
↪ Nucleoli that are present but less prominent than in myeloblasts
↪ Cytoplasm with primary (azurophilic) granules

What is the size of a myelocyte, and how does its nucleus appear?
12-18 μm in size. Its nucleus is reduced in size due to nuclear chromatin condensation and is round, oval, or slightly flattened on one side.

How do the nucleoli appear in a myelocyte?
indistinct and absent from this stage onward.

What is the appearance of the area next to the nucleus in a myelocyte?
clear light area next to the nucleus, which is the Golgi apparatus.

What is the hallmark feature of a myelocyte's cytoplasm?
appearance of secondary granules.
Where do the secondary granules first appear in a myelocyte?
in the Golgi apparatus
What are the microscopic features of a myelocyte?
↪ Intermediate N:C ratio (with more cytoplasm than a promyelocyte)
↪ Eccentrically placed oval nucleus with more mature (clumped) chromatin
↪ Perinuclear clearing is common
↪ Nucleoli absent
↪ More cytoplasm with rare or absent primary granules

What is the size of a metamyelocyte, and how does its nucleus appear?
10-18 μm in size, with a coarse and clumped nuclear chromatin. The nucleus has a kidney bean shape due to nuclear indentation.
Are nucleoli present in a metamyelocyte?
No, nucleoli are not visible
What is the appearance of the cytoplasm in a metamyelocyte?
neutral pink in color, with a predominance of secondary and secretory granules.

What types of granules are present in a metamyelocyte's cytoplasm?
secondary (specific) neutrophilic granules, which are lilac in color, and tertiary granules are synthesized during the metamyelocyte and band stages.

What are the microscopic features of a metamyelocyte?
↪ Intermediate N:C ratio (with more cytoplasm than a promyelocyte)
↪ Kidney bean-shaped nucleus
↪ Perinuclear clearing is common
↪ Nucleoli absent
↪ More cytoplasm with secondary (specific) neutrophilic granules

What is the size of a band neutrophil, and how does its nucleus appear?
9-15 μm in size, and its nucleus has an indentation greater than half the diameter of the hypothetical round nucleus, resulting in a horseshoe shape.
How does the nucleus of a band neutrophil compare to that of a mature neutrophil?
has a deeper indentation, creating a horseshoe shape.

What is the appearance of the cytoplasm in a band neutrophil?
pink to tan in color and contains granules.

What type of granules are found in the cytoplasm of a band neutrophil?
contains secondary (specific) neutrophilic granules, which are lilac in color.

What are the microscopic features of a band neutrophil?
↪ Low N:C ratio
↪ Horseshoe-shaped nucleus with indentation
↪ Nucleoli absent
↪ More cytoplasm with secondary (specific) neutrophilic granules

What is the size of a segmented neutrophil, and how does its nucleus appear?
9-15 μm in size, with a nucleus that is segmented into three to five lobes connected by a thin nuclear filament. Most have three or four lobes.

What is the difference between a hyposegmented and a hypersegmented neutrophil?
hyposegmented neutrophil has fewer than three lobes
hypersegmented neutrophil has more than five lobes

More than three neutrophils with five lobes are considered ________ in a 100-cell differential.
pathogenic
How does the chromatin of a segmented neutrophil appear?
condensed

What is the appearance of the cytoplasm in a segmented neutrophil?
pink or tan to clear, containing many secondary granules, tertiary granules, and secretory vesicles.

What do the granules in a segmented neutrophil contain?
lipids, carbohydrates, and proteins.
What markers are positive for a segmented neutrophil?
positive for CD11b/18
What are the microscopic features of a segmented neutrophil?
↪ Low N:C ratio
↪ Mature nucleus segmented into three to five lobes
↪ Nucleoli absent
↪ More cytoplasm with secondary granules
↪ Secondary (neutrophilic) granules are lilac in color

What is the primary function of neutrophils in host defense?
crucial for host defense by migrating from peripheral blood into tissues, where they engulf and destroy foreign agents
How do neutrophils contribute to the innate immune response?
Phagocytosis
Degranulation
Netosis

What is granulocytopenia?
decrease in all types of granulocytes.
What is neutropenia?
decrease specifically in neutrophils.
What is agranulocytosis?
absence of granulocytes, which significantly increases the risk of infections
What is granulocytosis?
increase in all granulocytes.
What is neutrophilia, and what conditions can cause it?
increase in neutrophils
often seen in conditions such as bacterial infections, metabolic/drug intoxication, and tissue damage/necrosis
What is the first step in phagocytosis by neutrophils?
recognition and attachment, where neutrophils recognize and bind to pathogens.
How do neutrophils engulf pathogens during phagocytosis?
extend pseudopods to enclose the pathogen within a phagosome
What occurs during phagosome maturation in neutrophils?
phagosome fuses with the lysosome, forming a phagolysosome for pathogen degradation
How do neutrophils kill pathogens during phagocytosis?
kill pathogens using reactive oxygen species (ROS), nitrogen species, and enzymes to degrade and kill the invader
What happens after the pathogen is degraded in phagocytosis?
pathogen is broken down into smaller fragments and expelled by the neutrophil
What are neutrophil extracellular traps (NETs) composed of?
DNA and proteins
What is the role of NETs in the immune response?
trap, neutralize, and kill bacteria, fungi, viruses, and parasites, preventing the spread of microbes without the need for phagocytosis
How do NETs contribute to microbial defense?
trap microbes and neutralize them, playing a crucial role in eradicating infections and preventing the spread of pathogens
What type of granules are present in an eosinophilic myelocyte, and how do they appear?
large, eosin-staining crystalloid granules, which are reddish-orange and spherical in shape.
These granules are larger than neutrophil granules and are uniform in size and evenly distributed

What is the nuclear-to-cytoplasmic (N:C) ratio in an eosinophilic myelocyte?
N:C ratio is low, meaning there is more cytoplasm relative to the nucleus.

How mature is the nucleus in an eosinophilic myelocyte?
slightly less mature and usually has one lobe.
Nucleoli may be present depending on the stage of maturation.
What color do the secondary granules in an eosinophilic myelocyte stain, and how do they appear?
eosinophilic, meaning they stain red-orange in color.

How many lobes does the nucleus of an eosinophil typically have?
2 or 3 lobes

What is the appearance of the cytoplasm in an eosinophil?
completely filled with granules, specifically large, eosin-staining crystalloid granules that are uniform in size and evenly distributed.

What is the nuclear-to-cytoplasmic (N:C) ratio in an eosinophil?
low, meaning the cytoplasm makes up a larger proportion of the cell compared to the nucleus

How mature is the nucleus in an eosinophil?
mature and usually has 2 lobes connected by a thin chromatin filament. Nucleoli are absent

What color do the secondary granules in an eosinophil stain, and how do they appear?
eosinophilic

What types of infections do eosinophils defend against?
defend against parasitic infections (such as helminths) and are involved in allergic reactions and hypersensitivities (such as asthma and anaphylaxis).

How do eosinophils contribute to immune defense?
attack parasites by releasing cytotoxic chemicals, including major basic protein (MBP).
Why is it impossible for eosinophils to engulf large multicellular parasites?
they instead attack them by releasing cytotoxic chemicals.

How does basophil maturation compare to neutrophil maturation?
similar to neutrophil maturation, with a gradual indentation and segmentation of the nucleus from the basophilic myelocyte to the segmented form

What is the nuclear-to-cytoplasmic (N:C) ratio in a basophil?
N:C ratio in a basophil is low

How many lobes does the nucleus in a basophil typically have?
mature, usually with 2-3 lobes connected by a thin chromatin filament. Nucleoli are absent

What is the appearance of basophil granules?
dark purple and obscure the background of the cytoplasm and the nucleus. They contain peroxidase and are positive for periodic acid-Schiff stain (PAS)

What role do basophils play in allergic responses?
release histamine and heparin, which are important in allergic responses and inflammatory reactions. They bind to IgE antibodies, contributing to hypersensitivity reactions.

How are basophils activated?
activated when IgE antibodies attach, triggering degranulation, which releases enzymes that are vasoactive, bronchoconstrictive, and chemotactic.

What is the primary role of monocytes?
host defense, which is fulfilled in tissues as macrophages.